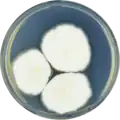
Aspergillus latus growing on CYA plate

| Aspergillus latus | |
|---|---|
| Scientific classification | |
| Domain: | Eukaryota |
| Kingdom: | Fungi |
| Division: | Ascomycota |
| Class: | Eurotiomycetes |
| Order: | Eurotiales |
| Family: | Aspergillaceae |
| Genus: | Aspergillus |
| Species: | A. latus |
| Binomial name | |
| Aspergillus latus (Thom & Raper) A.J. Chen, Frisvad & Samson (2016)[1] | |
| Synonyms | |
Aspergillus latus is a species of fungus in the genus Aspergillus in the Nidulantes section.[1]
Taxonomy
The species was first published in 1939 as a variety of Aspergillus nidulans. It was described as separate species in 2016.[1] At the same time, Aspergillus montenegroi and Aspergillus sublatus were found to be homotypic synonyms of A. latus,[1] however as of August 2023, they continue to be listed as accepted species in Index Fungorum.
Ecology
Strains of A. latus have been found worldwide from a variety of sources, notably soil, foods and in association with plants such as Geranium nepalense and Erica.[1]
Growth and morphology
A. latus has been cultivated on both Czapek yeast extract agar (CYA) plates and Malt Extract Agar Oxoid® (MEAOX) plates. The growth morphology of the colonies can be seen in the pictures below.
Aspergillus latus growing on CYA plate
Aspergillus latus growing on CYA plate Aspergillus latus growing on MEAOX plate
Aspergillus latus growing on MEAOX plate
References
- 1 2 3 4 5 6 7 8 9 10 Chen, A.J.; Frisvad, J.C.; Sun, B.D.; Varga, S.; Kocsubé, S.; Dijksterhuis, J.; Kim, D.H.; Hong, S.-B.; Houbraken, J.; Samson, R.A. (2016). "Aspergillus section Nidulantes (formerly Emericella): Polyphasic taxonomy, chemistry and biology". Studies in Mycology. 84: 1–118. doi:10.1016/j.simyco.2016.10.001. PMC 5198626. PMID 28050053.
- ↑ Page Names Record (Aspergillus nidulans var. latus Thom & Raper) on "Species Fungorum". Index Fungorum. Retrieved 2023-08-31.